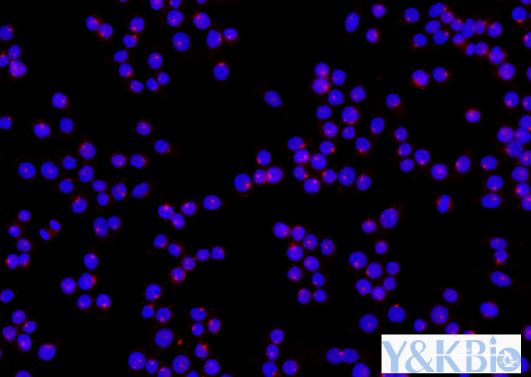

产品中心
联系我们
陕西依科生物技术服务有限公司首页 > 普通病理学服务 > 吉林免疫荧光单标染色
免疫荧光染色是陕西依科生物特别推出的宽病理染色服务,免疫荧光染色是根据抗原抗体反应的原理,先将已知的抗原或抗体标记上荧光素制成荧光标记物,再用这种荧光抗体(或抗原)作为分子探针检查细胞或组织内的相应抗原(或抗体)。免疫荧光染色主要是在细胞或组织中形成的抗原抗体复合物上含有荧光素,利用荧光显微镜观察标本,荧光素受激发光的照射而发出明亮的荧光(黄绿色或桔红色),可以看见荧光所在的细胞或组织,从而确定抗原或抗体的性质、定位,以及利用定量技术测定含量。
免疫荧光染色实验原理
将不影响抗原抗体活性的荧光色素标记在抗体(或抗原)上,与其相应的抗原(或抗体)结合后,在荧光显微镜下呈现一种特异性荧光反应。
一、吉林免疫荧光单标染色详情介绍:
免疫学的基本反应是抗原-抗体反应。由于抗原体反应具有高度的特异性,所以当抗原抗体发生反应时,只要知道其中的一个因素,就可以查出另一个因素。免疫荧光技术就是将不影响抗原抗体活性的荧光色素标记在抗体(或抗原)上,与其相应的抗原(或抗体)结合后,在荧光显微镜下呈现一种特异性荧光反应。
二、免疫荧光单标染色图片
1. 细胞cd206

2.脑组织GFAP
(1)DAPI

(2) GFAP

(3)Merge
三、实验流程:
1. 吉林石蜡切片脱蜡至水:依次将切片放入二甲苯Ⅰ20min-二甲苯Ⅱ20min-无水乙醇Ⅰ5min-
无水乙醇Ⅱ5min-75%酒精 5min,自来水洗;
2. 抗原修复:组织切片置于盛满柠檬酸(PH6.0)抗原修复液的高压锅内进行抗原修
复,喷气计时 2.5min, 自然冷却后将玻片置于 PBS(PH7.4)中在脱色摇床上晃
动洗涤 3 次,每次 5min;
3. BSA 或者血清封闭:切片稍甩干后用组化笔在组织周围画圈(防止抗体流走),在圈内滴
加用5%BSA,室温封闭 1h;
4. 加一抗:轻轻甩掉封闭液,在切片上滴加按一定比例配好的一抗,切片平放于湿盒内4°C
孵育过夜(湿盒内加少量水防止抗体蒸发);
5. 加二抗:玻片置于PBS(PH7.4)中在脱色摇床上晃动洗涤 3 次,每次8min。切片稍甩
干后在圈内滴加与种属对应的二抗,覆盖组织,室温孵育 120min。之后玻片置于 PBS
(PH7.4)中在脱色摇床上晃动洗涤 3 次,每次 8min;
6. DAPI 染核:滴加DAPI,室温孵育10min,之后玻片置于PBS(PH7.4)中在脱色摇床上
晃动洗涤 3 次,每次 6min;
7. 封片:抗荧光淬灭剂封片;
8. 镜检拍照:切片于荧光显微镜下观察并采集图像。(DAPI 紫外激发波长330-380nm,发射波
长420nm,发蓝光;FITC激发波长465-495nm,发射波长515-555 nm,发绿光;CY3激发波长
510-560,发射波长590nm,发红光)。
四、染色结果判读:DAPI染出来的细胞核在紫外的激发下为蓝色,阳性表达为相应荧光素标记的红
光或者绿光